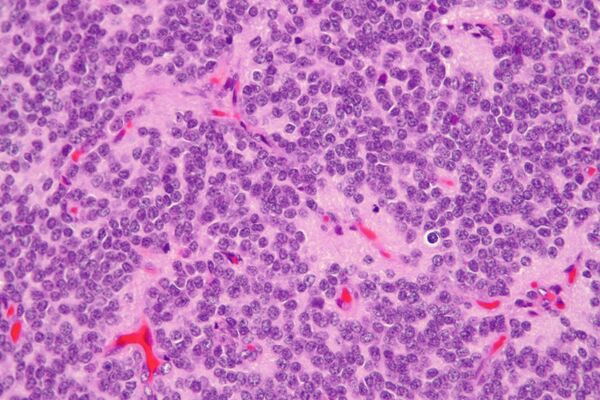

Центральная нейроцитома
Центральная нейроцитома — чрезвычайно редкая, обычно доброкачественная внутрижелудочковая опухоль головного мозга, которая обычно образуется из нейрональных клеток прозрачной перегородки.[1] Большинство центральных нейроцитом прорастают внутрь в желудочковую систему. Это приводит к двум основным неврологическим симптомам: нечеткости зрения и повышению внутричерепного давления. Лечение центральной нейроцитомы обычно включает хирургическое удаление с вероятностью рецидива примерно в 1 из 5 случаев.[2] Центральные нейроцитомы классифицируются как grade II опухоли в соответствии с классификацией опухолей нервной системы ВОЗ.[3][4]
Что важно знать
| Центральная нейроцитома |
|---|
Эпидемиология
Центральная нейроцитома составляют 0,1-0,5% первичных опухолей головного мозга.[5][6] В формировании этих опухолей есть генетический компонент, из-за которого у людей азиатского происхождения образуется эта опухоль развивается чаще, чем у представителей других этнических групп.[7] Центральные нейроцитомы преимущественно образуются у молодых людей, чаще всего в течение второго или третьего десятилетия жизни.[8] Нет никаких доказательств того, что пол человека каким-либо образом влияет на частоту центральных нейроцитом.[7]
Локализация
Центральные нейроцитомы обычно располагаются супратенториально в боковом желудочке(боковых желудочках) и/или третьем желудочке. Наиболее частым местом является передняя часть одного из боковых желудочков с последующим распространением в другой боковой и третий желудочки. Вовлечение прозрачной перегородки вероятно является особенностью опухоли.[9] Изолированное поражение третьего и четвертого желудочков встречается редко.[10]
Симптомы
Спектр жалоб пациентов с нейроцитомой обширен, большинство из них обусловлены обструктивной гидроцефалией, вследствие закупорки тока ликвора по желудочковой системе головного мозга. Наиболее частые симптомы:[11]
- Повышение внутричерепного давления
- Головная боль
- Отек диска зрительного нерва
- Рвота
- Головокружение
- Нарушение умственной деятельности
- Нестабильность походки
В редких и крайних случаях могут наблюдаться более серьезные симптомы:
- Нарушение памяти
- Слабоумие
- Гемипарез
- Судороги
- Кровоизлияние
- Психоз
Морфология
Макроскопически центральная нейроцитома имеет сероватый цвет, напоминающий серое вещество с участками кровоизлияния. Опухоль мягкой консистенции, овоидной формы, дольчатого или узловатых строения, которые обычно четко очерчены. На разрезе можно отметить некоторую шероховатость, которую связывают с кальцификацией.
Микроскопически опухоль представляет собой хорошо дифференцированное новообразование с доброкачественными гистологическими особенностями. Опухоль состоит из «одинаковых клеток малого и среднего размера с округлыми ядрами, мелко пунктирным хроматином и незаметными ядрышками, а также скудной цитоплазмой». Опухоль характеризуются периваскулярными и похожими на пинеоцитоматозные псевдорозетками, которые напоминают цветы расположением клеток, с небольшим кровеносным сосудом в центре. Опухолевые клетки расположены плотно в некоторых областях опухоли, но другие области являются безъядерными, менее плотными частями опухоли. Безъядерные области могут иметь тонкий фибриллярный матрикс , как и в областях нейропиля. Длинные тонкостенные сосуды размером с капилляр являются сосудистой системой нейроцитомы. Эти сосуды линейно разветвляются и имеют эндокринный вид. Тонкостенные расширенные сосудистые каналы, а также очаги кальцификации встречаются часто.[11]
Дифференциальный диагноз проводят с олигодендроглиомой.